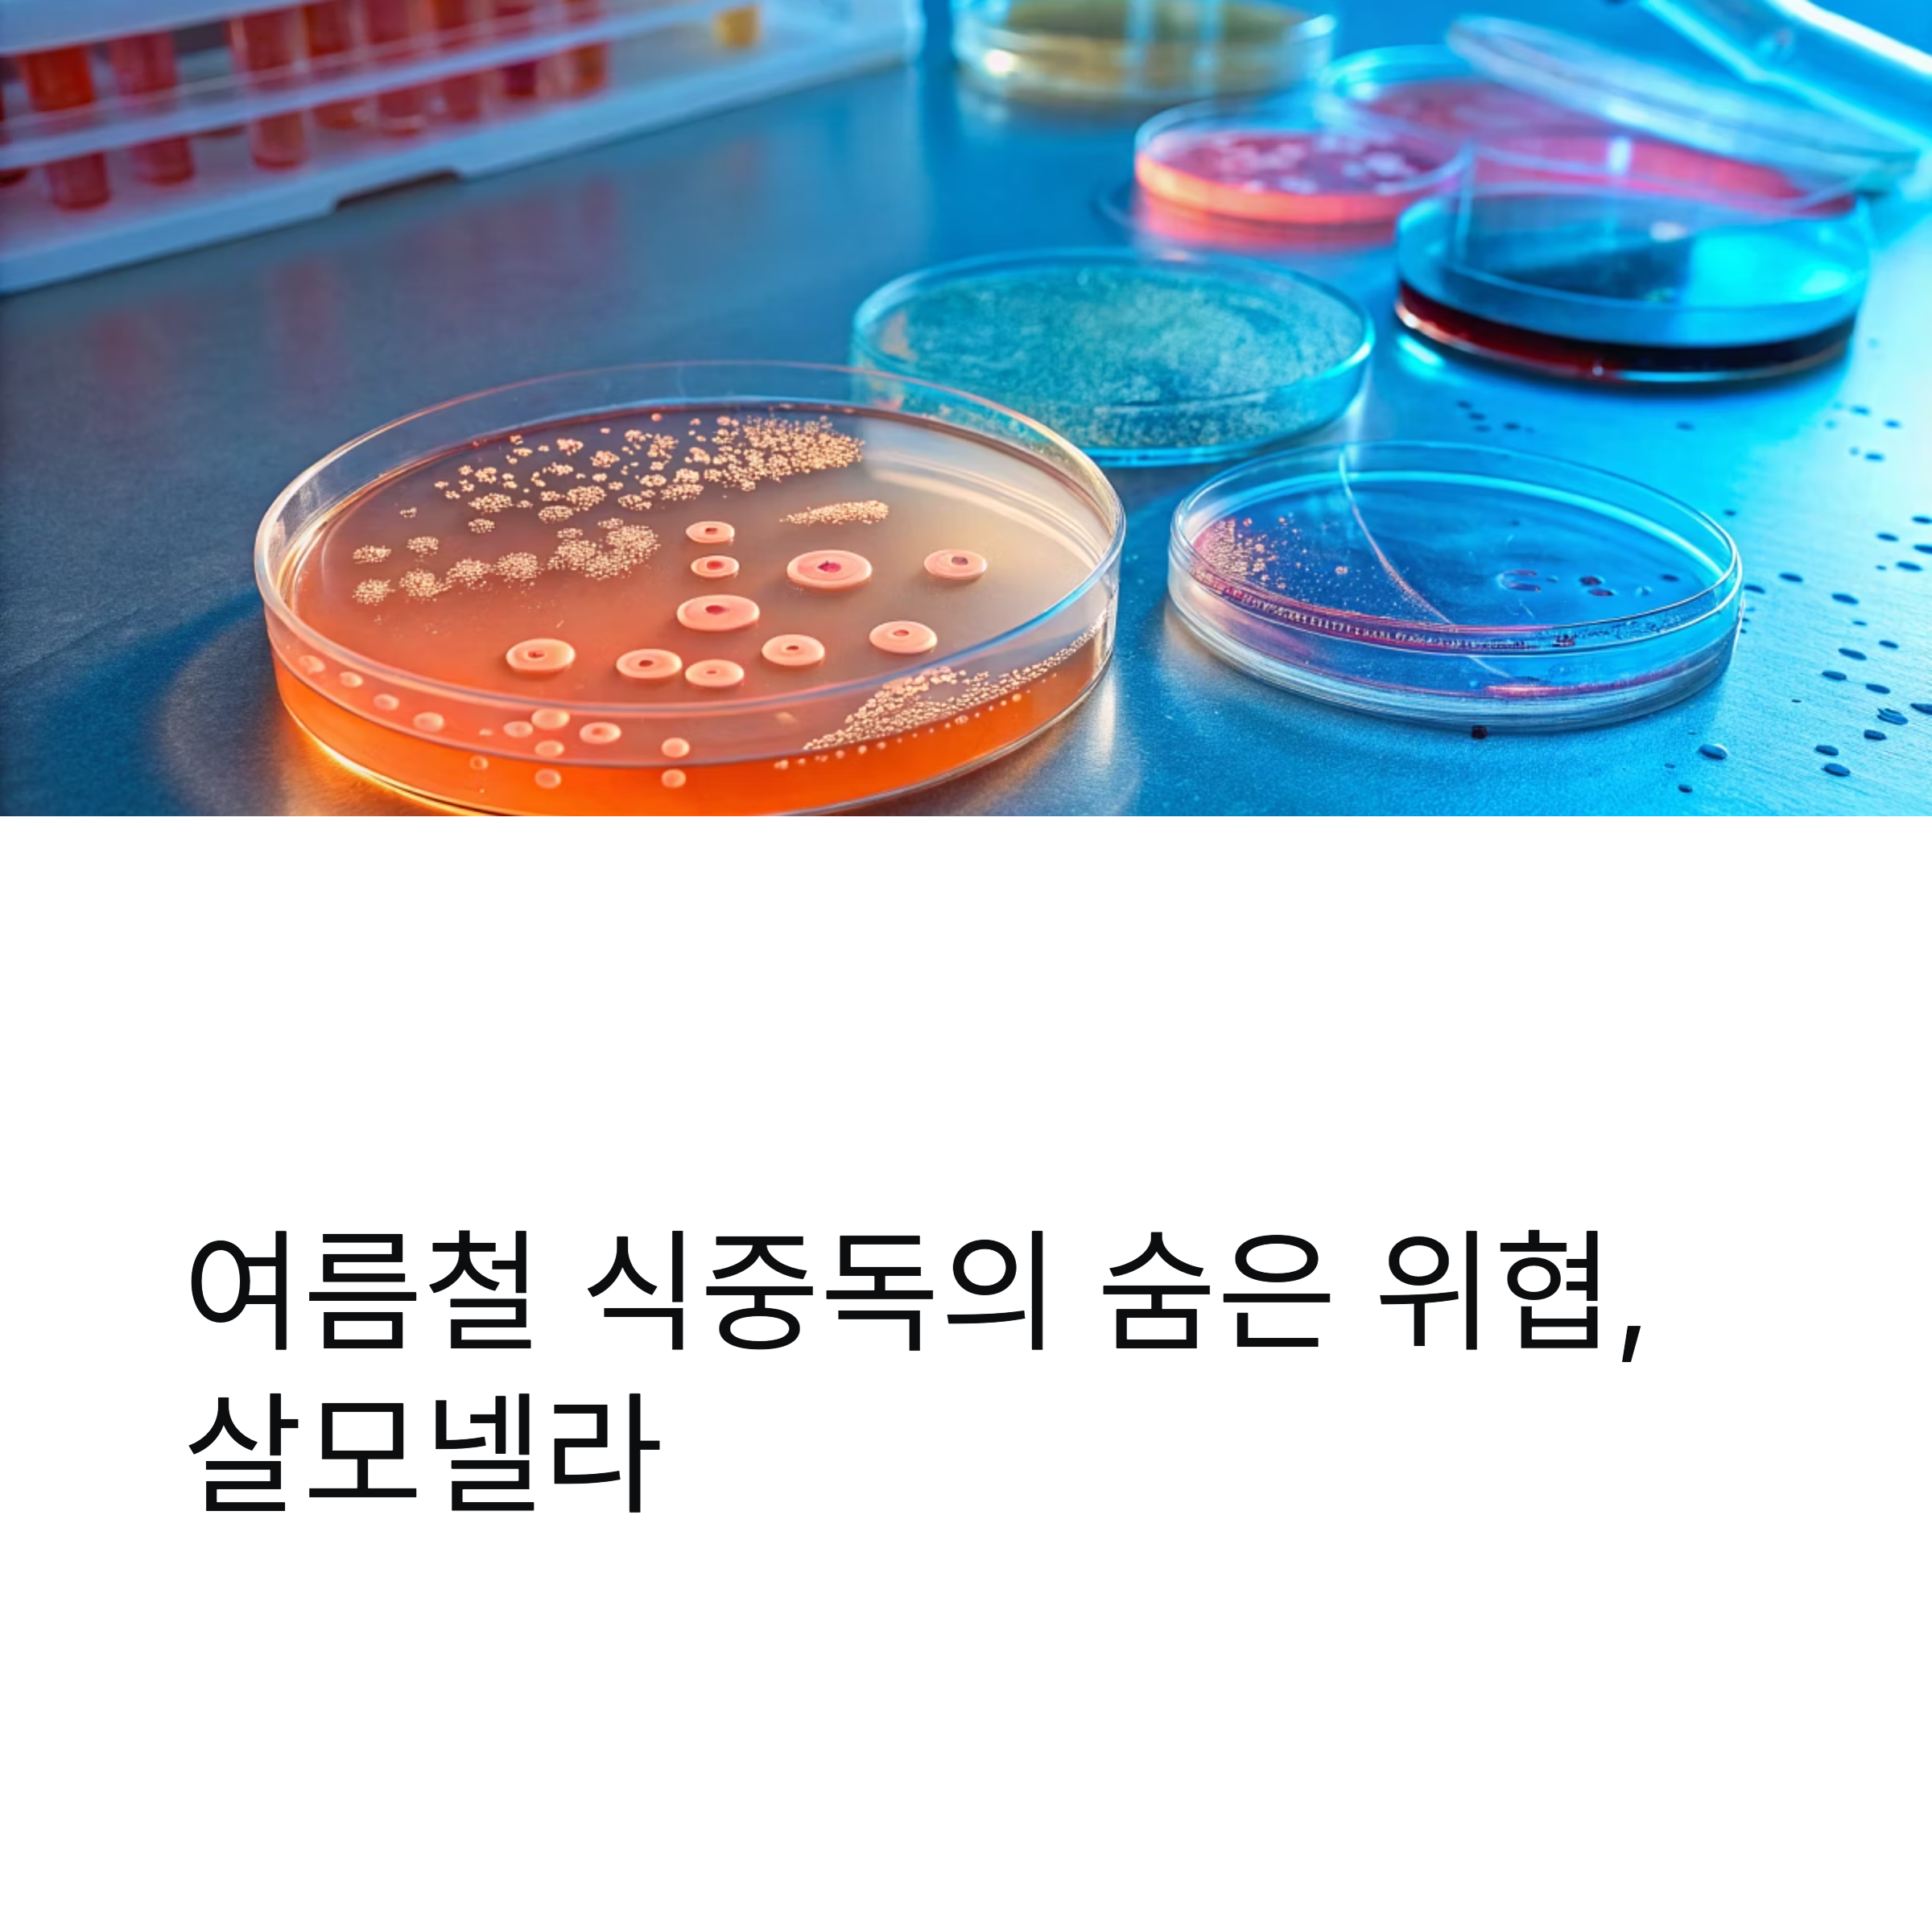
여름철 식중독의 숨은 위협, 살모넬라

매년 늘어나는 살모넬라 감염, 방심하면 안 되는 이유는?
여름은 세균성 장관감염증이 폭증하는 계절입니다. 특히 살모넬라균은 고온다습한 기후에서 번식력이 매우 뛰어나고, 여름철 식재료와 급식 환경에서 빠르게 퍼질 수 있어 더욱 주의가 필요합니다. 최근 5년간 데이터를 살펴보면 감염자 수가 매년 증가하고 있으며, 2024년 7월 넷째 주에는 역대 최다 감염자 수를 기록할 만큼 경각심이 필요한 상황입니다.

살모넬라 감염자 수, 왜 매년 급증하고 있나?
살모넬라균은 여름철 기온 상승과 함께 번식 속도가 급격히 빨라지며
조리 과정에서 오염이 쉬운 식품을 통해 사람에게 전파됩니다. 특히
달걀 기반 음식이나 도시락, 김밥류에서 자주 검출되며, 학교나 음식점
같은 다중이용시설에서의 집단감염으로 이어지기 쉽습니다.
2024년 7월 한 달간 세균성 장관감염증 환자 수는 502명으로
전년 동기 대비 크게 증가했습니다.

세균성 감염 중 살모넬라 비중은 몇 퍼센트?
최근 4주간 살모넬라균 감염 비율은 전체 세균성 감염증의 약 29.1%를 차지하며
노로바이러스의 12%를 크게 웃돌았습니다. 특히 7월 넷째 주 기준,
살모넬라 환자는 146명으로 나타나며, 가장 많은 감염은 캄필로박터균이었지만
살모넬라 또한 매우 높은 수치를 기록했습니다.
아래는 주요 병원체별 감염 현황입니다.
구분 감염자 수 감염 비율
| 살모넬라균 | 146명 | 29.1% |
| 캄필로박터균 | 227명 | 45.2% |
| 노로바이러스 외 기타 | 129명 | 25.7% |

감염 경로는 어디서부터 시작될까?
살모넬라균은 가금류나 포유동물 장 내에 주로 기생하며,
달걀이나 고기를 중심으로 감염 경로가 형성됩니다.
껍질이 손상된 달걀이나 제대로 익히지 않은 계란지단,
도시락에 들어가는 반숙 계란이 주요 오염원이 되며,
한 번 오염되면 손이나 조리도구를 통해 교차 감염이
빠르게 이루어질 수 있습니다.

조심해야 할 고위험 식재료는?
식중독 발생과 가장 연관 있는 식품군은 다음과 같습니다.
식품 유형 주요 오염 사례
| 달걀 조리식 | 계란말이, 계란지단 등 |
| 김밥류 | 계란지단, 어묵, 햄 포함 시 |
| 도시락류 | 달걀 포함 반찬, 고기류 |
| 육류 | 익히지 않은 고기 또는 육즙 오염 |
달걀 껍질의 미세한 균열도 세균의 침투 경로가 될 수 있으므로
선별과 보관 단계부터 철저한 위생 관리가 필요합니다.

예방을 위한 실천 수칙, 알고 계신가요?
실제 예방은 조리 전후 위생관리에서 시작됩니다.
살모넬라균은 70도 이상의 열에서 사멸되므로 음식은 반드시
충분히 익혀야 하며, 조리도구도 용도별로 분리해 사용해야 합니다.
예방을 위한 기본 수칙은 다음과 같습니다.
예방 수칙 설명
| 손씻기 | 달걀 만진 후 30초 이상 비누로 손씻기 |
| 보관 | 달걀과 육류는 냉장 보관, 구입 즉시 보관 |
| 조리 | 70도 이상에서 음식 충분히 익히기 |
| 식사 | 조리 후 2시간 이내 섭취, 남은 음식은 냉장보관 |

정부의 위생 점검, 어떻게 이뤄지고 있나?
식품의약품안전처는 2025년까지 전국 1,400여 식용란 업체를
대상으로 정기 위생 점검을 실시 중입니다.
살모넬라균 오염 여부 확인을 위해 700건 이상의 식용란 샘플을
수거해 검사하고 있으며, 위반 업체에는 행정처분 및 제품 회수 조치를
신속히 취하고 있습니다.

식중독 환자 절반, 어디에서 발생했을까?
2024년 집계에 따르면 식중독 환자 6,800명 중 54%가
일반 음식점에서 발생했고, 그 다음은 학교(14%)와
어린이집·유치원(10%)에서 발생했습니다.
특히 여름방학 기간 중 도시락, 간편식 이용이 증가하면서
살모넬라 감염 위험이 높아지는 양상이 관측됩니다.

여름철 장관감염증, 어떻게 대비해야 할까?
가정에서도 음식 보관 및 위생관리에 철저해야 하며,
특히 야외활동이나 도시락을 준비할 경우,
조리 후 즉시 섭취하고 남은 음식은 2시간 이내 냉장보관이 필요합니다.
깨끗한 물로 채소를 씻고 껍질 벗겨 섭취하는 습관 또한 중요합니다.
감염병은 예방이 최우선이라는 사실, 잊지 마세요.
'우리몸지키미' 카테고리의 다른 글
| 감염병 주의 시기, 여름에 가장 조심할 점은? (5) | 2025.06.20 |
|---|---|
| 식중독 예방, 손 씻기보다 중요한 건? (2) | 2025.06.20 |
| 피부로 시작하는 고지혈증, 조기 발견법 (1) | 2025.06.14 |
| 알티지 오메가3 vs 일반 오메가3, 차이는 무엇인가? (1) | 2025.06.14 |
| 방광염 증상, 남성에게 더 위험할 수 있습니다 (8) | 2025.06.14 |